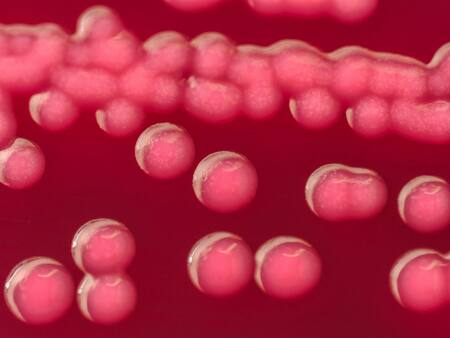
Bacterias de escherichia coli. Foto: Unsplash

"Vampirismo bacteriano": existen bacterias que usan la sangre humana como alimento y pueden afectar a la salud
Algunas muy conocidas, como la escherichia coli, anhelan el suero sanguíneo humano como fuente de alimento.

El "vampirismo bacteriano", como fue bautizado por los expertos, tiene muy preocupados a los investigadores en la salud humana, luego de que la Universidad Estatal de Washington descubriera que ciertas bacterias se sienten atraídas por la sangre y la utilizan como comida.
Los científicos encontraron evidencia que algunas bacterias que causan enfermedades, incluidas cepas de escherichia coli, son atraídas químicamente por el suero de nuestra sangre como fuente de alimento.
Bacterias de escherichia coli. Foto: Unsplash
Los investigadores se centraron en tres gérmenes en particular: Salmonella, Citrobacter koseri, y escherichia coli. Las tres bacterias son un desencadenante común de hemorragia intestinal y bacteriemia, siendo una de las principales causas de muerte de personas con enfermedades inflamatorias intestinales
Los patógenos mencionados son las principales causas de mortalidad en los individuos con enfermedades intestinales: "Al aprender cómo estas bacterias son capaces de detectar fuentes de sangre, en el futuro podríamos desarrollar nuevos fármacos que bloqueen esta capacidad", señaló uno de los investigadores.

Bacterias de salmonella. Foto: Unsplash
El mismo científico explicó que "las bacterias son organismos microscópicos que no tienen ojos ni oído. Pero sí tienen algo análogo al sentido del olfato. El sentido del olfato que tienen las bacterias es un comportamiento llamado quimiotaxis. Una de las principales funciones de la quimiotaxis es buscar alimento".
El estudio arrojó conclusiones espeluznantes
Para sus experimentos, los científicos utilizaron cepas de bacterias tomadas de pacientes reales. Para estimular el sangrado intestinal, utilizaron suero sanguíneo humano y un “dispositivo de microfluidos personalizado basado en inyección”.
Para sorpresa de los expertos, el germen fue atraído casi instantáneamente, tomando menos de un minuto, para identificar la presencia de suero cerca y comenzar a avanzar hacia él.

Atraídas por la sangre. Foto: Unsplash
Otros experimentos con salmonella encontraron evidencia de que esta locomoción fue impulsada al menos en parte por las bacterias que detectan un aminoácido particular abundante en el suero llamado L-serina. Y también descubrieron que las bacterias eran realmente capaces de alimentarse del suero.
Los hallazgos demuestran que algunas bacterias están finamente sintonizadas para buscar nuestra sangre y así nutrirse. El “vampirismo bacteriano" parece aclarar por qué estas bacterias son una causa común de infecciones del torrente sanguíneo.


















